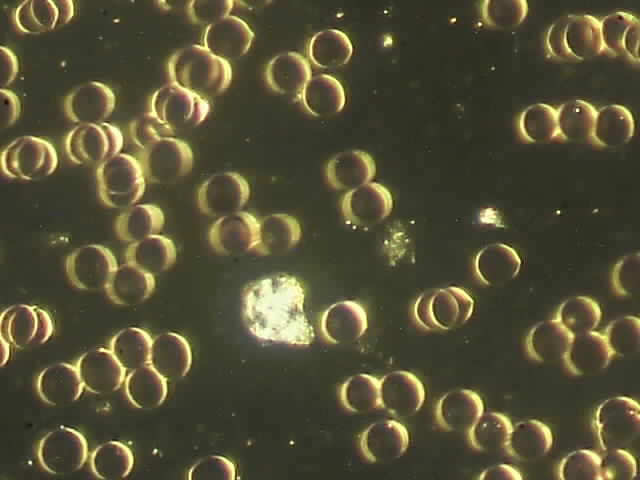

Therapeutensuche
Wählen Sie die Kategorie:
Wählen Sie das Verfahren:
Wählen Sie das Land:
Im Umkreis von:
von:
Stichwort (optional):
Zertifizierte Osteopathen
Soziales Honorar
Fremdsprache
Online-Fernberatung
Naturheilpraxis an der Laach

Hp. Lothar Schütten
Unterstr. 5
53859 Niederkassel Rheidt
| Telefon: | 02208 50 60 366 |
| Handy: | 0171 36 49 640 |
| Web: | www.hpschuetten.de |
Klassische und Alternative Heilverfahren
Praxiszeiten:
Montag, 10:00 bis 18:00 Uhr
Dienstag, 09:00 bis 18:00 Uhr
Mittwoch, 09:00 bis 15:00 Uhr
Donnerstag, 09:00 bis 18:00 Uhr
Freitag, 09:00 bis 15:00 Uhr
nach Vereinbarung
Leistungsspektrum:
Traditionelle und komplementäre Medizin, Heilkunde
Akupunktur
Allergiebehandlung
Augenakupunktur
Ausleitungsverfahren
Baunscheidt-Verfahren
Blutegeltherapie
Blutuntersuchung
Chiropraktik
Dunkelfelddiagnose
Ernährungstherapie
Homöopathie
Kinesiotaping
Klinische Untersuchungsmethoden
Ohrakupunktur
Pflanzenheilkunde
Rheumatherapie
Schmerztherapie
Schröpfen
Taping
Psychologische Beratung
Arbeit mit Bach-Blüten
Verantwortlich für den Inhalt des Eintrages ist:
Hp. Lothar Schütten